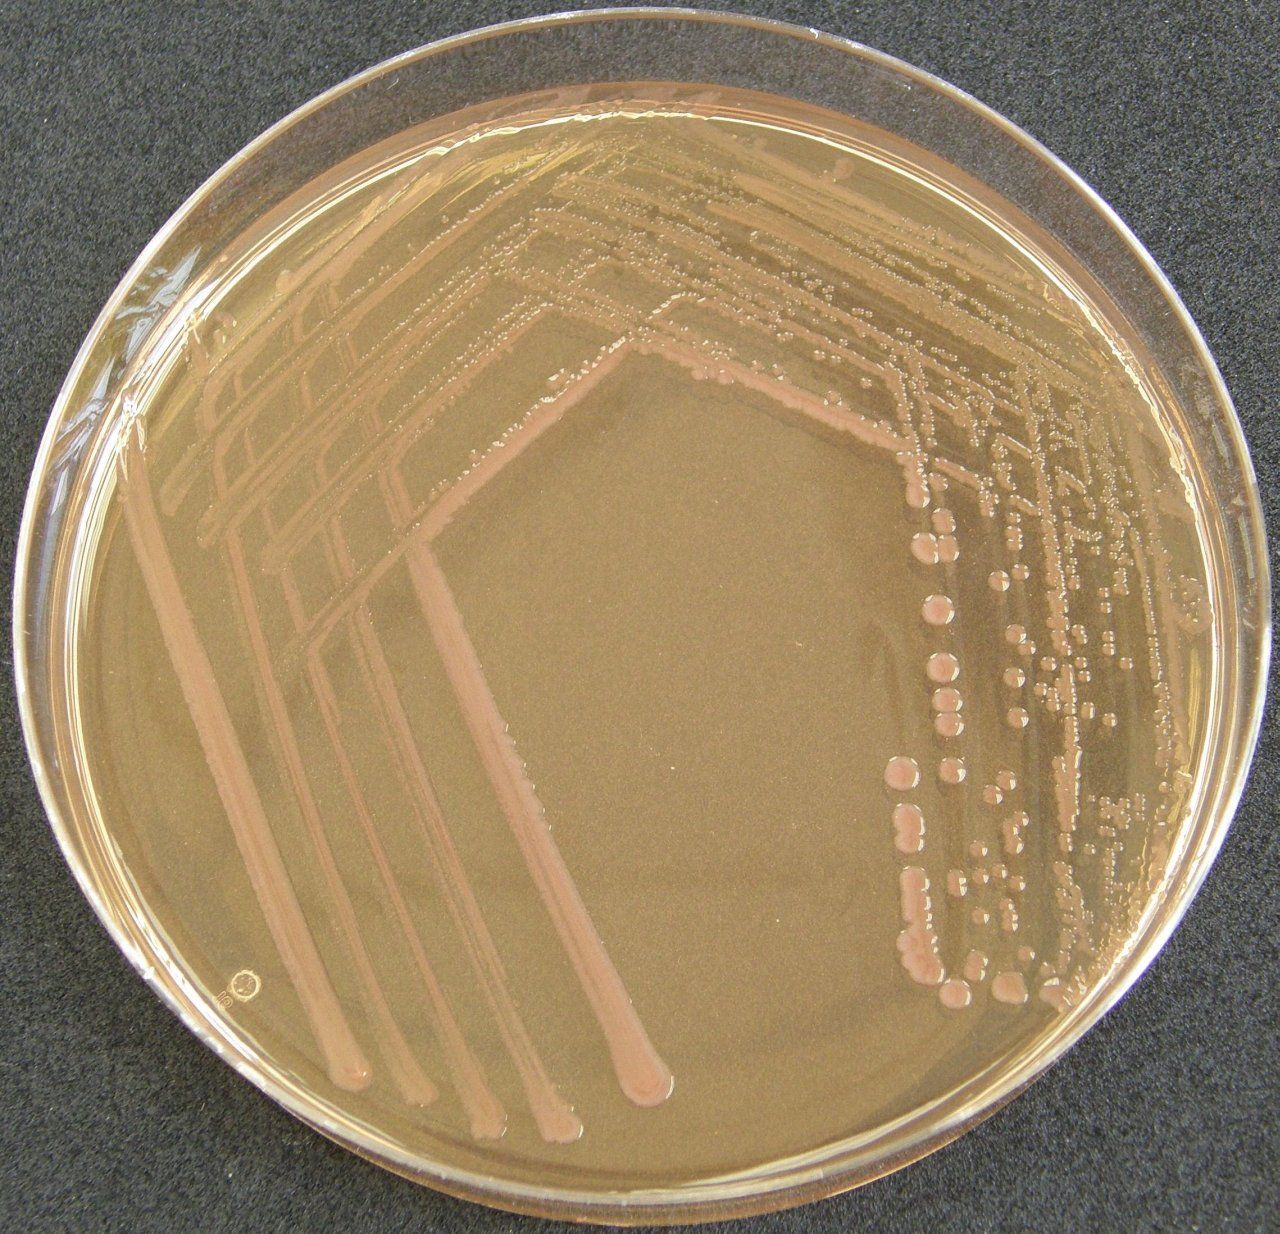
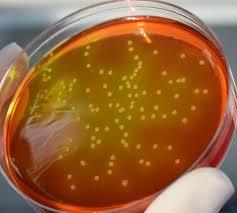

Шигелла бульон
Слива неженка опылители
Ленинградская обл погода на 3 дня
Причины плача просто так
Приказ о целевом обучении 2025
Математика 3класса 2часть стр 75 номер 5
Остаток пакета минут мтс
Автомобиль б у ульяновск
Как защитить стены в бане
Реклама редми нот 8 про
Анимированные приветы
Приготовление пашины
Форма проведения педагогического совета
Выключить сигнализацию старлайн с брелка
Шигелла бульон 143 фото